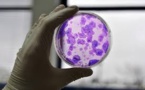
USA: 570 cliniques proposent des soins non-autorisés avec des cellules souches

|
3600 Résultats pour votre recherche : promotion-(h87.cc)-promotion->>h87.cc
La Tahiti Pearl Regatta, 40 heures de diffusion à l'internationalMarie Caroline Carrère | 13/07/2016 | Actualité de Tahiti et ses îles
L'avenue Pouvana’a a Oopa bloquée ce jeudiD'après un communiqué | 12/07/2016 | Actualité de Tahiti et ses îles
Les pistes de la nouvelle politique familialeMélanie Thomas | 05/07/2016 | Actualité de Tahiti et ses îles
Tahiti Mahana Beach : Le Pays constate l'échec de son accord avec le Chinois RecasJean-Pierre Viatge | 03/07/2016 | Actualité de Tahiti et ses îles
La Tahiti Moorea Sailing a rassemblé 70 voiliersDelphine Barrais | 01/07/2016 | Actualité de Tahiti et ses îles
APF: 122 bacheliers ayant reçu la mention "très bien" médaillés() | 01/07/2016 | Actualité de Tahiti et ses îles
Complexe aquacole de Hao : 10 Polynésiens en formation à ShanghaiMélanie Thomas | 28/06/2016 | Actualité de Tahiti et ses îles
Élection de Miss Tahiti 2016 : qui succédera ce soir à Vaimiti Teiefitu ?Dominique Schmitt | 24/06/2016 | Actualité de Tahiti et ses îles
900 millions de francs de subventions pour Tahiti TourismeJacques Franc de Ferrière | 23/06/2016 | Actualité de Tahiti et ses îles
TEDx Papeete : "Le tourisme a de l'avenir en Polynésie"Amelie David | 23/06/2016 | Actualité de Tahiti et ses îles
Le timbre "street-art" en Polynésie à la conquête de New-York [Vidéo]D'après un communiqué | 22/06/2016 | Actualité de Tahiti et ses îles
"Le Cnam se met au service de la Polynésie"Jacques Franc de Ferrière | 21/06/2016 | Actualité de Tahiti et ses îles
|
|
|||
|
TAHITI-INFOS est un site édité par FENUACOMMUNICATION Sarl au capital de 20 000 000 Fcfp, immeuble Manarava - Shell RDO Faa'a - BP 40160 98 713 Papeete Polynésie Française.
(+689) 40 43 49 49 - Dir. de publication : Sarah MOUX - Gérant : Albert MOUX |
||||

![Le timbre "street-art" en Polynésie à la conquête de New-York [Vidéo] Le timbre "street-art" en Polynésie à la conquête de New-York [Vidéo]](https://www.tahiti-infos.com/photo/art/imagette_16_9/9726793-15684263.jpg?v=1466630516)







